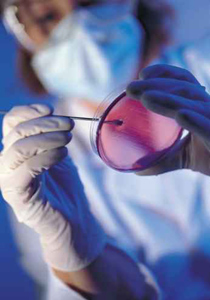

تمكن فريق من العلماء البريطانيين من إيجاد طريقة جديدة لعلاج مرض سرطان الجلد من خلال استخدام العلاج الجيني فيما أعرب العلماء عن الاعتقاد أنهم حققوا انجازا غير مسبوق في استخدام الجينات في مكافحة الأورام السرطانية. الباحثين في جامعة ستراثكلايد استخدموا طريقة جديدة لإيصال الجينات إلى الأورام صعبة المنال دون إحداث أي أضرار بالخلايا السليمة إذ أن طريقة البحث والتدمير حققت نتائج مذهلة.
|
|
الطريقة العلاجية أدت إلى نتائج |
ونقلت الإذاعة عن الدكتورة كريستين دوفيس من معهد الصيدلة والعلوم الطبية الحيوية في جامعة ستراثكلايد التي قادت فريق الباحثين قولها إن هذه الطريقة العلاجية أدت إلى نتائج واعدة لعلاج السرطان في الاختبارات الأولية التي أجريناها.
وكان أطباء بريطانيون قد رحبوا قبل شهور قليلة بالاكتشاف الطبي الكبير الذي تمكن من خلاله علماء بريطانيون وآخرون من كسر الشفرة الجينية الكاملة لاثنين من أكثر السرطانات انتشارا في العالم هما سرطانا الرئة والجلد مبينين أن ذلك يشكل فتحا علميا باهرا قد يحدث ثورة في طريقة تشخيص وعلاج هذا المرض القاتل.
وقال الدكتور بيتر كامبل من معهد هنغستون لأبحاث السرطان في مقاطعة كامبرج شاير شمال انجلترا انه على الرغم من المشوار الطويل لتحقيق الحلم بالقضاء على مرض السرطان إلا أن اكتشاف جينات المرض من شأنه أن يسهل الأمر لتطوير أدوية جديدة تستهدف الجينات المسببة للسرطان.















